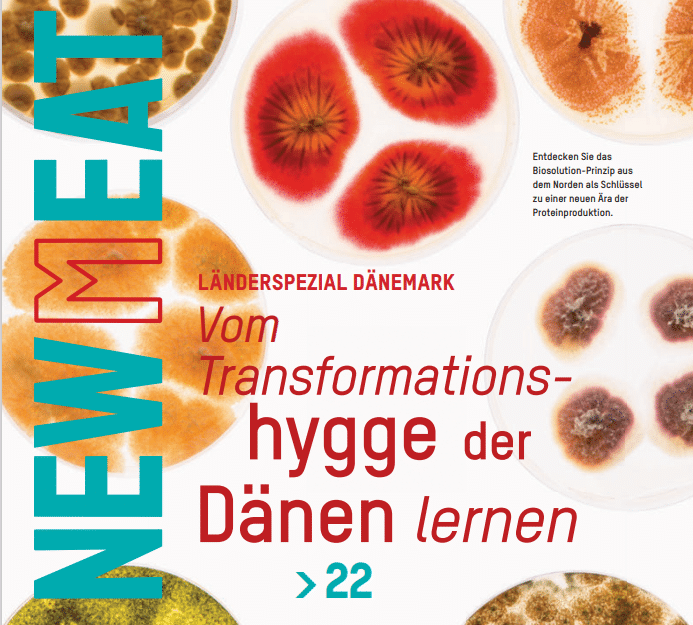

Redefine Meat
in the News
All our latest headlines
-
12/08/2024A few weeks after launching it flagship flank steak into European retailers, Redefine Meat co-founder Eshchar Ben-Shitrit talks early feedback, navigating the UPF debate and...
-
15/07/2024Redefine Meat has launched a brand-new plant-based flank steak I absolutely love steak but have always considered veganism The plant-based flank steak has a meaty...
-
03/07/2024'New meat' firm marks European retail launch of premium plant-based protein with listings in Ocado and Coop Switzerland
-
03/07/2024This is the first time a plant-based flank steak will be available for consumers to buy and cook at home, after previously being reserved for...
-
07/02/2024Processed foods are often describedas high in salt, fat, sugar, calories andpreservatives. But are all processed foods bad, and are they all created equal? What...
-
06/02/2024Introducing Plant-Based Tissue Engineering (PBTE): a novel approach replicating the texture and taste of traditional meat using plant-based ingredients. By deconstructing and reconstructing meat components...
-
29/09/2023Israel’s Redefine Meat is known for its unique “new-meat” technology, said to be able to replicate any cut of meat in plant-based form. Since the...
-
21/09/2023At present, the Israeli plant-based meat supplier principally sells into foodservice.
-
14/07/2023Redefine Meat is accelerating its UK distribution to meet demand with eight wholesaler partners. Its UK wholesalers now span national and regional brands including Albion...
-
20/04/2023Redefine Meat won the 2023 Clio Awards Bronze Prize in the Animation category for 'THE COW REPURPOSING INSTITUTE' campaign
-
06/02/2023Redefine Meat’s 3D-printed vegan steaks, tenderloins, and lamb shanks are expanding across Europe to kick off a new era of center-of-the-plate proteins.
-
17/01/2023Why shouldn’t we give it the chance to compete with the real thing?
-
30/12/2022At the annual Food Tech Israel conference held in Tel Aviv on Nov. 7, exhibitioners offered samples of hydroponically-grown vanilla, reduced-sugar sugar, protein bars with...
-
24/11/2022Is Google's latest AI chatbot really "sentient"? Will we one day have to contend with "killer robots"? Is augmented reality the future of art galleries?...
-
19/10/2022The arrival of veggie meat dishes on Parisian steakhouse menus with names such as "tenderloin" and "flank" poses a challenge to French government efforts to...
-
13/10/2022Israel's Redefine Meat has struck a partnership with importer Giraudi Meats to drive European distribution of its "New Meat" steak cuts produced on 3D printers,...
-
06/10/2022Redefine Meat will unveil innovation across its entire product range, endorsed by leading chefs and butchers, further boosting the growth of the New-Meat category in...
-
20/09/2022Israel’s Redefine Meat, known for its 3D-printed plant-based whole cuts, is presenting its new Redefine New-Meat™ Bratwurst at Oktoberfest 2022. The news comes shortly after...
-
12/09/2022Israeli plant-based meat maker Redefine Meat has announced its expansion into Finland, via a partnership with local meat alternative manufacturer and distributor MeEat. The tie-up...
-
09/09/2022Redefine Meat announces a partnership with plant-based manufacturer and distributor, MeEat, to distribute Redefine Meat’s range to restaurants in Finland. MeEat will offer Redefine Meat’s...
-
16/08/2022There is a long, global history of the manipulation of foods to make them resemble other foods, from mock turtle soup to mock duck to...
-
08/08/2022The brand is pioneering an advanced type of plant-based protein and eyeing international expansion
-
12/07/2022Collaboration represents one of the largest and most ambitious plant-based sustainability initiatives with Redefine Meat and any hospitality chain to date. Menus to feature Redefine...
-
28/06/2022New-Meat pioneer, Redefine Meat, is continuing its collaboration with legendary chef Marco Pierre White, as a further 23 MPW restaurants across the UK to incorporate...
-
28/06/2022With texture-identical cuts and 3D-printed joints, meat substitutes are advancing fast. Here are the next level plant-based foods
-
25/04/2022As the animal products we consume continue to have an impact on the environment, could the key to repairing some of that damage lie in...
-
25/04/2022In this episode, Natty is joined by CEO and founder of Redefine Meat Eshchar Ben-Shitrit, who shares how his love of cooking began, what led...
-
21/04/2022Selfridges has launched a retail experiment at its flagship store in Oxford Street, London, where customers can have a glimpse at what an “eco-conscious shop...
-
30/03/2022Ayala Meidan, Global Marketing Manager at Redefine Meat, imagined how our plates might look one day when speaking at Mind the Tech 2022 in London
-
25/03/2022Eshchar Ben-Shitrit made the remarks at Calcalist's Mind the Tech London 2022 conference. "Meat is not going to disappear. Why? Because it's really tasty. We're...
-
22/02/2022Famous chef Marco Pierre White is now offering 3D printed vegan steaks at his Steakhouse Bar and Grill in Plymouth, UK. The steaks are made...
-
11/02/2022Innovations in the field of sustainability and why there is a push in the food market for alternatives.
-
10/02/2022With the launch of Redefine Meat’s plant-based products simultaneously in London, Berlin and Amsterdam in November 2021, 3D-printed meat has arrived in Europe. We took...
-
08/02/2022As the race quickens to provide diners with the best meat alternatives, one start-up is producing so-called 'whole cuts' of plant-based meat using 3D printers.
-
07/02/2022We invite you to listen to the experience of a BBC journalist in the Chotto Matte event, starting in minute 8 of the podcast
-
02/02/2022Two former HP Indigo product managers are poised to scale up their radical plans to become the world’s biggest plant-based meat company, using 3D printed...
-
02/02/2022Engineers are fine-tuning the machines and materials for customizable cuisine and personalized nutrition
-
01/02/2022One of the threats to the world’s ecological balance is meat production. According to a report by the UN Food and Agriculture Organization (FAO), 14.5%...
-
31/01/2022Israeli startup Redefine Meat Ltd. has raised $135 million in new funding for its roll out of 3D-printed plant-based steaks across Europe amid rising demand...
-
23/01/2022The Israeli company will use the funds to set up production lines in Israel and the Netherlands, sources inform "Globes."
-
18/11/2021Israeli startup Redefine Meat expanded operations into Europe where it hopes to reach thousands of restaurants by the end of next year and served for...
-
18/11/2021Could 3D-printed meat taste the same as fillet steak? Israeli company Redefine Meat, which uses 3D-printing technology to replicate the taste of beef and lamb,...
-
17/11/2021Diners will soon be able to eat 3D-printed vegan “steaks” at celebrity chef Marco Pierre White’s restaurants across the UK. The acclaimed chef says he...
-
16/11/2021Israeli startup Redefine Meat on Tuesday expanded operations into Europe where it hopes to reach thousands of restaurants by the end of next year and...
-
16/11/2021Company brings to market what was previously considered technologically impossible: commercial-scale whole cuts of plant-based meat, achieving a level of quality endorsed by leading chefs...
-
16/11/2021Company says 3D-printed beef substitute — mix of soy and pea protein, chickpeas, beetroot, nutritional yeasts and coconut fat — will broaden appeal of alternative...
-
16/11/2021Israeli food-tech pioneer Redefine Meat has launched what was previously considered “technologically impossible” for plant-based meat – whole cuts of 3D-printed vegetable meat that “bleed”...
-
16/11/2021Across four capitals – London, Amsterdam, Berlin and Tel Aviv – a new meat was born, containing precisely no animal. The London champion of the...
-
16/11/2021Start-up says it has cracked the secret of juiciness in meat including plant-based beef and lamb flanks
-
16/11/2021Startup also unveils first ‘whole cuts’ for high-end restaurants in the UK, Germany, Netherlands
-
08/11/2021Speaking at Tech TLV, Co-Founder and CEO of Redefine Meat Eshchar Ben Shitrit talks about flexitarian desires
-
17/10/2021“The Israeli companies' success in developing meat substitutes will not only be an economical one. It will also have a significant impact on our ability...
-
14/10/2021Redefine Meat Ltd, the ‘New-Meat’ pioneer, announced today a major coup with two new high-profile business leadership appointments as part of the company’s aggressive global...
-
14/10/2021A company focused on “new meat” has hired some seasoned experts to shepherd its growth. Tel Aviv, Israel-based Redefine Meat, Ltd. recently named Edwin Bark...
-
14/10/2021Redefine Meat Ltd, the ‘New-Meat’ pioneer, announced today a major coup with two new high-profile business leadership appointments as part of the company’s aggressive global...
-
07/10/2021Alternative meat substitutes hitting the market are challenging ‘bland veggie’ food stereotypes A vegan future is probably inevitable. Animals will eventually get their moment when...
-
09/08/2021Israeli food tech startup Redefine Meat announced plans this week to commercially launch its plant-based alternative meat products in the UK and elsewhere in Europe...
-
30/07/2021With slogans like ‘A whole different animal,’ and ‘Precisely the same, entirely different,’ startup unveils its high-end, plant-based 3-D printed products at Tel Aviv tasting
-
30/07/2021In recent years, several initiatives to develop 3D printed meat have emerged. Among these projects is Redefine Meat, an Israeli startup founded in 2018. Using...
-
30/07/2021The company is one of the pioneers in the 3D printed food industry, using advanced scientific analysis to develop a vegetable-based 3D printed “meat-like” product....
-
29/07/2021Redefine Meat, the food brand that promised a 3D printed plant-based “beef” revolution in Israel, announced the commercial launch of its first-ever series of five...
-
28/07/2021Redefine Meat, which makes plant-based meat alternatives using 3D printing and is preparing to launch in Europe after announcing a $29m fundraise at the start...
-
28/07/2021Food tech company Redefine Meat has announced it will launch its range of 3D printed vegan meat products in the UK later this year, Its...
-
27/07/2021Kebab? Burger? Bolognese? There’s a product for that
-
27/07/2021With slogans like ‘A whole different animal,’ and ‘Precisely the same, entirely different,’ startup unveils its high-end, plant-based 3-D printed products at Tel Aviv tasting
-
27/07/2021Israeli food tech company Redefine Meat has confirmed it will launch its range of 3D printed vegan meat alternatives in the UK before the end...
-
27/07/2021Plant-based meat company Redefine Meat announced five new products are now available at select Israeli restaurants and hotels. The “New-Meat” line consists of Redefine Burger,...
-
27/07/2021Redefine Meat, a food 3D printing firm developing animal-free meat, has commercially launched its first-ever series of ‘New-Meat’ products to selected restaurants and hotels in...
-
27/07/2021Redefine Meat is on track for a commercial launch of its New-Meat plant-based products in its home market of Israel. In Q4 of this year,...
-
27/07/2021Redefine Meat is on track for a commercial launch of its New-Meat plant-based products in its home market of Israel. In Q4 of this year,...
-
30/06/2021In an interview with the CEO of Redefine Meat, we learn about how 3D printing can be used to make ‘new meat,’ and more
-
24/06/2021Eshchar Ben-Shitrit, the CEO of Israel's Redefine Meat, which makes plant-based meat alternatives using 3D printing, talks its prospects for success in creating a scalable...
-
15/06/20213D-printed steaks, bacon made from mushrooms, and fermented plant-based beef. What's the future of plant-based meat?
-
10/06/2021With a projected market size of $290bn by 2035 and an ever increasing awareness surrounding animal welfare and the environment, the alternative protein market is...
-
21/05/2021Food technology is no longer the preserve of lab-bound boffins. These days innovators are taking products to market themselves – and cashing in
-
06/05/2021Alon Bar-Shany is making the leap from color printers to printing steaks out of protein substitutes. In an interview, he admitted he eats real meat,...
-
06/04/2021From plant equivalents to cultured cells, Israeli startups are winning the race to cruelty-free meat. But no one knows whether 3D-printed steaks are kosher
-
26/03/2021Can these 4 companies overcome the triple challenges of product texture, pricing, and regulation in the quest to transform the food industry’s holy grail?
-
24/03/2021With industry feedback indicating that meat reduction and flexitarianism has slowed amid the ongoing pandemic, we talk to Eshchar Ben-Shitrit, CEO and Co-Founder of meat...
-
01/03/2021One firm called 'Redefine Meat' has set itself the goal of producing that sensation, but meat free, and has raised $29 million to launch a...
-
16/02/2021Israeli start-up Redefine Meat is planning to launch its 3D-printed meat substitutes globally after raising $29 million in a funding round led by venture capital...
-
16/02/2021The Israeli company says its products duplicate the texture, taste and culinary experience of beef by solely using plant-based ingredients.
-
22/01/2021Israel’s Redefine Meat today announces it has carried out the largest-scale public blind-tasting of Alt-Meat products to meat-eaters, to what it calls unprecedented success.
-
21/01/2021Blind taste-test hailed a success, Best Meister to distribute plant-based substitute to restaurants and high-end butchers in Israel
-
21/01/2021Israeli start-up Redefine Meat has pulled off the ‘world’s largest’ blind taste test for its 3D printed meat alternative. The taste test targeted meat-eaters and...
-
01/12/2020Redefine Meat has spent several years examining the muscle structure to determine a formal way to engineer and 3D print different styles of meat.
-
22/11/2020The inherent advantages of 3D printing make it a perfect fit for solving some of the most complex challenges in replacing animals as a source...
-
12/11/2020Daniel Dikovsky, Head of Innovation and Technology at Redefine Meat, explains why the inherent advantages of 3D printing make it a perfect fit for solving...
-
22/07/2020Twenty high-impact agtech and foodtech early scaleups have been selected to join EIT Food’s RisingFoodStars Association, a pan-European network that provides its members with tailored...
-
21/07/2020An Israeli startup, Redefine Meat, is planning to launch 3D printers that will produce beef-like plant-based “Alt Steaks” for consumers.
-
07/07/2020Amid lifestyle changes toward wellness and health, as well as an inclination of industries to adopt disruptive technologies, the 3D printed plant-based meat industry could...
-
01/07/2020Redefine Meat Unveils Its First 3D Printed Vegan Steak Product – ALT-STEAK™
-
01/07/2020Plant-based burgers are one thing, but a fake steak that can convince meat eaters is a much harder accomplishment. Redefine Meat thinks it’s figured it...
-
09/06/2020Redefine Meat targets meat-lovers with 3D printed plant-based solutions: We're Closer than you thinkSurging awareness about plant-based products has seen a proliferation of meat analogues hitting the market. But to truly appeal to ‘meat-lovers’, Redefine Meat CEO and...
-
01/05/2020Evolving plant-based meat to bridge the gap for meat lovers: with environmental concerns, global supply chain crises and food security risks taking centre stage worldwide...
-
28/11/2019The walls of Redefine Meat Ltd.’s lab in Rehovot, Israel, are plastered with posters of cuts of beef, including sirloins, T-bones, and rib-eyes. Books such...
-
19/11/201915 revolutionary startups took to the stage to pitch ground-breaking, sustainable solutions for the food and agriculture (F&A) industry at FoodBytes! by Rabobank yesterday. The...
-
15/10/2019Faux meat is generating breathless headlines these days. The days of real meat are numbered, they would have you believe - you can’t even tell...
-
14/09/2019Israel-based Redefine Meat, which develops technology for 3D printing alternative meat products, announced the completion of a $6 million seed round Wednesday The alternative meat...
-
14/09/2019Redefine Meat, the Israeli company developing technology to 3D print plant-based meat, today announced that it had raised a $6 million seed round led by...
-
14/09/2019An Israeli company looking to revolutionize the food industry with a 3D printable meat alternative has taken a major step towards its goal. The company,...
-
09/09/2019In researching this column, I was astonished to learn how carnivorous we Israelis are. According to an OECD study on per capita meat consumption, Israel...
-
21/08/2019This week, diners at a fancy restaurant in Israel were served an elegantly plated kebab, garnished with an eye-catching swipe of crimson sauce and thin...
-
03/07/2019Livestock farming contributes significantly to global warming through releases of methane, a greenhouse gas 20 to 30 times more potent than carbon dioxide. It contributes...